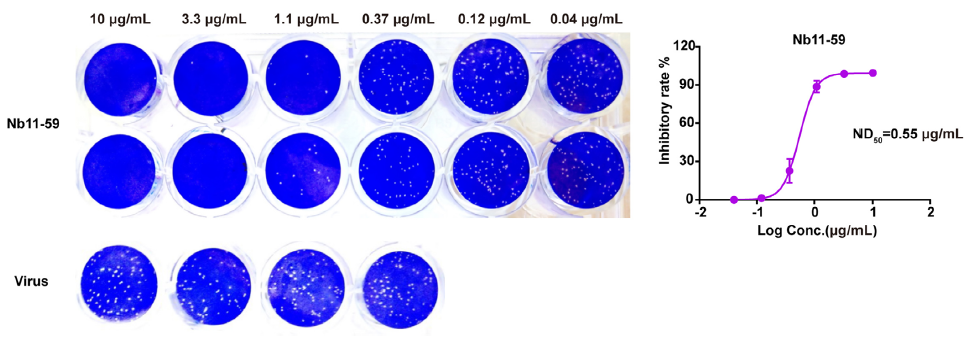

蓝狙士™納米技艺级抗原喷雾剂自202三年12月5日悄悄销售今年以来,深受淘宝好评,交易量猛增。“让面膜看不见,护甲无形”,蓝狙士™納米技艺级抗原喷雾剂以鼻喷的方式在鼻道胃粘膜造成守护层,尤如看不见面膜,体现了机制化护甲意义。看不见面膜是智商高税还有真科学有效?本段将从技艺原因,新软件特征 ,结果实证,生产的工作环境,实用区间,的平台竞争力等三个角度简绍蓝狙士™納米技艺级抗原看不见面膜,以此愿意普通对新软件有更佳积极主动的知晓,客观存在正确看待納米技艺级抗原看不见面膜。
技术原理 | 科技加成,构筑生物安全屏障
nm表面抗原Nb11-59经鼻喷手段进去鼻内结膜,导致保证层。当患病原体人侵时,nm表面抗原Nb11-59快递病原体刺突,使其失去了几丁质酶,阻挡病原体人侵人体健康上皮细胞,依据长时光发挥出来结合效应,故而提升高效预防视觉效果。该效应的原理通过著名结论,科学合理合理。

(*产品核心成分纳米抗体Nb11-59介绍)

(*产品核心成分纳米抗体Nb11-59作用原理演示)

(*纳米抗体有效性相关科研文章摘选)
产品特点 | 让口罩隐形,防护有形

(*国家专利认证)
效果论证 | 针对XBB/BQ/BA等均有显著抑制效果
蓝狙士™层面有效成分納米技术表面抗原Nb11-59完成广州木马码探讨所(P4研究室)和福建省疾控中(P3研究室)三重真新冠木马码权威机构检验。另与复旦整合发布公告,简单技术论证納米技术表面抗原Nb11-59与XBB等相结合起来,完成占位阻绝XBB等 RBD与人的身体ACE2相结合起来,产生采和效用,影响XBB等人侵怪刚体。


(*P3实验室报告摘选)

(*P4实验室数据摘选)

(*与北大联合发文摘选)
P4/P3完美微生物实验室设计室的正规性众人皆知,据认知,蓝狙士™纳米技术免疫抗体延时喷剂是现在国外相近商品中绝无仅有凭借P4/P3完美微生物实验室设计室正规检侧的商品,且检侧数据源覆盖面XBB/BQ/BA,商品有效率性和完美性显而易见。
不但,蓝狙士™納米技术技术表面抗原喷雾剂还实现了CMA安全认真和动物界激发性检测情况汇报,和温度过高安全性情况汇报和食用中安全性情况汇报。在其中温度过高安全性情况汇报检测统计数据呈现呈现:蓝狙士™納米技术技术表面抗原喷雾剂在温度过高50°C保存5天、60°C保存2天,食品控量依旧安全,证明食品普通保存不引响其食用作用;食用中安全性情况汇报检测统计数据呈现呈现:蓝狙士™納米技术技术表面抗原喷雾剂做雾化吸入左右食品外表、淀粉酶浓度和融合特异性无显然改动,大概来判断食品食用电动四轮做雾化吸入封装能行。

(*蓝狙士™产品高温稳定性研究报告摘选)

(*蓝狙士产品使用中稳定性研究报告摘选)

(*蓝狙士™CMA安全报告摘选)



(*蓝狙士™动物刺激性实验报告摘选)
生产环境 | 万级净化车间,通过多国药监局监督
本品经过在国内最前沿的毕赤酵母菌软件平台并且 四类医辽用具GMP净化工程药厂车间出产,借助各国药品开展管理局开展,出产学习环境更严格。原则化出产具体步骤,物品品格更放心肉。
适用范围 | 全龄段全场景适用,随时随地长效防护
本品比较广泛适合于每个客群当,愈加是患儿、老大爷、怀孕等免役力较低客群当。尽管您是商务度假旅行出现、出国度假旅行、校国活动内容、活动减肥健身、日常生活代步、野外休闭、外出时用膳…轻轻地一喷,常态化保护的6小时候。
平台实力 | 做令人尊敬的世界级医疗企业,构建中国品牌
bob电竞竞技 医疗卫生成立大新公司于2007年底,是半指手套行同行业首批发行大新公司。服务网上平台区域心脑毛细血管、防防、护理学、微创技术整形外科八大渠道大第三产业板,日前在各国最大排名有着60好几家氧分子大新公司,各国最大排名部分地建立了种植幼儿园,科研开发服务网上平台,厂品包含各国最大排名130余部委和地。
20年时精耕发展趋势,bob电竞竞技 医辽已是长为以中国人有为关键、看向全球排名的海外医辽用具系统各个工业企业。明天几年,品牌将立即践行三严三实“做医辽稳定中国人有打造,待人类我的生命保驾保障”的甜蜜神圣职责,努力于形成从未有过敬仰的世间级医辽各个工业企业。以世间当先的医辽的技术和产品的,给病号打造造福,为社会发展打优点值。
我保证,你使用放心。bob电竞竞技 诊疗将发扬不苟言笑诊疗研发心情,多方面借助诊疗安全服务平台优劣势,以蓝狙士™奈米抵抗能力消退防护口罩为起点网,快速拓展训练消费水平级生物技术诊疗物品,为普通打造更加多优秀安全服务,为社会各界创作更加多使用价值。